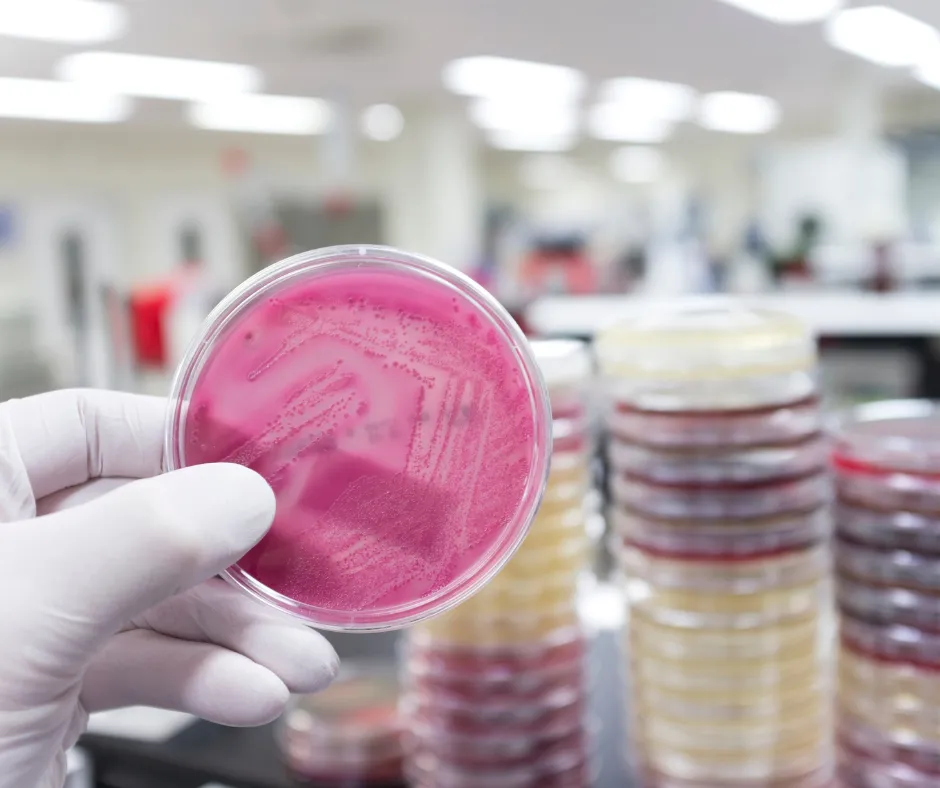

At Hazon Screening, we are committed to providing reliable, accurate, convenient comprehensive testing and screening services to individuals, families, and business.
Based in Baton Rouge, Louisiana, we proudly serve the local community through a combination of in-office and mobile testing solutions and offer nationwide services.
Whether you visit our Baton Rogue location or request on-site testing, our goal is to deliver fast, professional service with the highest standards of care and confidentiality. We work with individuals, schools, government agencies, and employers of all sizes to meet testing and compliance needs-locally and across the country.


Urine Testing
Hair Follicle Testing
Oral Fluid Testing
Fingernail Testing
Breath Alcohol Testing
Instant and Lab Based Drug Testing
DOT & Non-DOT Testing

Paternity DNA Testing
Non Invasive Prenatal Paternity Testing(NIPP)
Gender Reveal
Lifestyle DNA Analysis
Immigration DNA Testing
Infedelity DNA Testing
None Legal DNA Testing

Respirator Fit Testing
Pulmonary Function Testing
Audiometry Screening
Snellen Eye Exam
Ishihara Colorblindness Exam

Pre-Employment Physical
Sports Physical
School Enrollment Physical
Fit to Duty Physical
Return to Work Physical

Digital Fingerprinting
I-9 Verification
Badge Photos
Background Checks
CPR Training
Bloodborne Pathogens Training

Venipuncture
Capillary puncture
Routine blood collections
Lab test preparation and patient screening
Specimen labeling, handling, and transport
Point-of-care testing (as applicable)
Pregnancy testing
New services includes:

Accurate, fast, and confidential results
Friendly, experienced, and certified staff
Flexible options: in-office, mobile, and nationwide testing
One-stop shop for clinical and occupational health services
• National Criminal Data Base
• Sex Offender Registry
• SSN Offender Registry
• Everything in Basic and Standard Package
• 7-year County Criminal Record/ History
• Federal Court Records
•Everything in Basic,plus
• County Criminal Records (Current County)
Our clients may also add on any of the following to any package or order individually:
County Criminal Records - $24.95*
State Criminal Records - $19.95*
Federal Criminal Records - $14.95*
Sex Offender Registry - $11.95
Employment Verification - $19.95*
Education Verification - $19.95*
Motor Vehicle Report (MVR) - $24.95*
CDLIS - $12.95
Adverse Action Program - $19.95
PSP Report- $22.95
Professional License Verification - $19.95
Healthcare Sanctions Records - 18.95
SAMS Sanctions - $13.95
Social Security Verification - $7.95
*Additional fees may apply. Fees do not include third party cost.

Pre-Employment Physical
Sports Physical
School Enrollment Physical
Fit to Duty Physical
Return to Work Physical

Digital Fingerprinting
I-9 Verification
Badge Photos
Background Checks
CPR Training
Bloodborne Pathogens Training
Digital Fingerprinting
I-9 Verification
Badge Photos
Background Checks
CPR Training
Bloodborne Pathogens Training
Copyright 2026. Hazon Screening. All Rights Reserved.